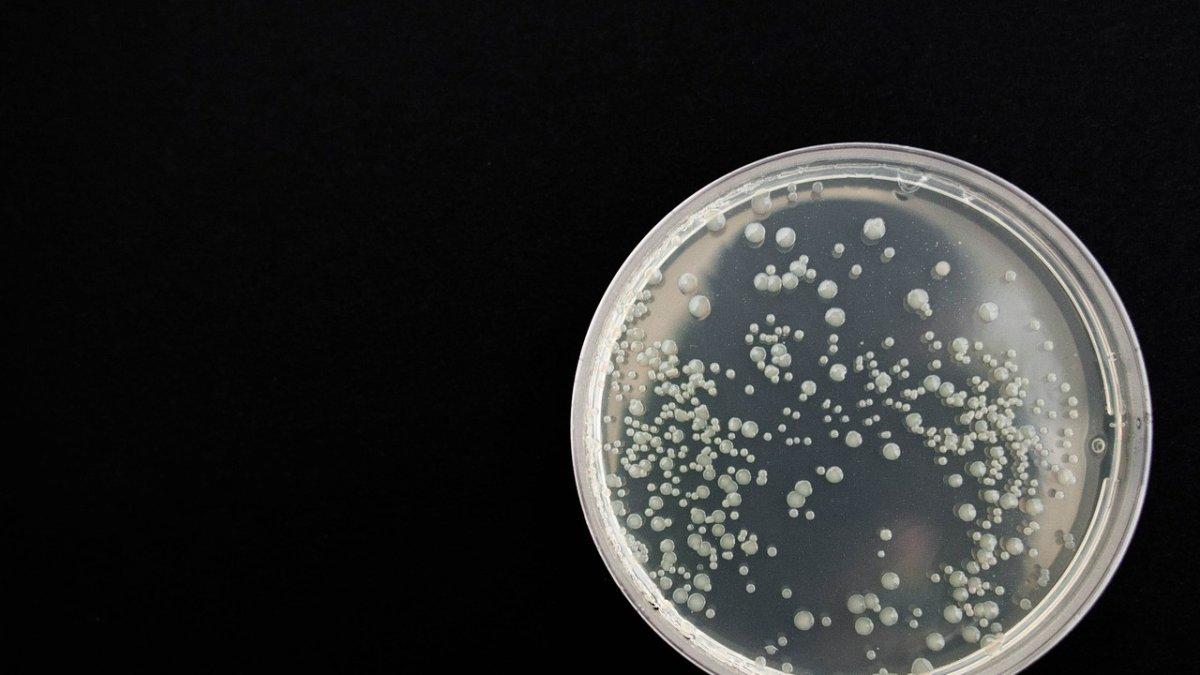
Un nuevo estudio científico halló novedades preocupantes sobre el comportamiento del coronavirus o COVID-19. Foto referencial.

El coronavirus se queda en el aire y vive hasta 72 horas en objetos
Un reciente estudio científico sobre el nuevo coronavirus o COVID-19 descubre nuevas características del causante de la actual pandemia.
Un nuevo estudio científico halló novedades preocupantes sobre el comportamiento del coronavirus o COVID-19. Foto referencial.
El coronavirus no es lo único que avanza, sino también las investigaciones científicas sobre este nuevo virus, también conocido como COVID-19. En esa línea, un nuevo estudio científico señala que, contrario a lo que se creía hasta hace poco, este virus permanece en el aire hasta por tres horas.
El estudio fue realizado por un equipo de científicos de los Centros para el Control y la Prevención de Enfermedades (CDC) de Estados Unidos y las universidades de California, Los Ángeles y Princeton. Se publicó esta semana en el New England Journal of Medicine.
Las novedades que arroja este estudio no solo se refieren a la permanencia del coronavirus en el aire hasta por tres horas, en estado de aerosol, sino que también se mantiene vivo más tiempo en ciertas superficies. Toma nota: hasta dos días en plástico y acero inoxidable y hasta por 24 horas en los cartones.
Ecuador
Coronavirus: El examen en laboratorios privados no puede superar los 120 dólares
Javier Montenegro
No obstante estos avances, se indicó que aún no se sabe si es que el coronavirus que se queda en el aire es contagioso o no. Sin embargo, expertos sugieren la prevención.
Es así que estos hallazgos llevan a repensar el uso de la mascarilla. De acuerdo al doctor Elmer Huerta, lo mejor sería llevar una a manera de precaución. En declaracciones a la radio RPP, Huerta indicó que la ciencia cambia y que ahora es mejor usar la mascarilla en la calle.
En tanto, en Ecuador, el número de infectados sigue en aumento. Infórmate aquí sobre todo lo relacionado al coronavirus en Ecuador y el mundo.